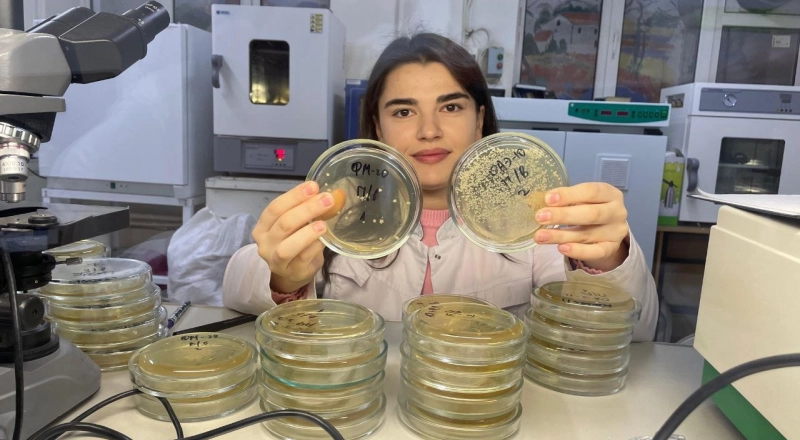
Ученые объяснили, почему леса Амазонки выделяют больше углекислого газа, чем поглощают

27 марта 2025
Ученые заменили нейросети простыми системами

24 марта 2025
В ТУСУРе разработали многолучевую антенную систему L-диапазона для станции СПСО КОСПАС-САРСАТ

24 марта 2025
В России создали ПО для цифрового двойника композитной ткани

24 марта 2025
Ученые ДГТУ создают инновационные полимербетонные станины

24 марта 2025
Разработчик и производитель: инструменты взаимодействия

20 марта 2025
Ставропольские химики синтезируют новые противомикробные и противоопухолевые вещества

20 марта 2025
В ПГУПС открыли новые образовательные пространства

19 марта 2025
Лаборатория ПИМУ прошла сертификацию на соответствие стандартам GLP
19 марта 2025
Ученые объяснили, почему леса Амазонки выделяют больше углекислого газа, чем поглощают

19 марта 2025
ИИ в биомедицине: новая магистерская программа от ТУСУРа

18 марта 2025
Инновационный способ утилизации нефтяных отходов от ученых Пермского Политеха

17 марта 2025
Уральские инженеры создали первый отечественный XRT-сепаратор

17 марта 2025
ПНИПУ: робот будет учить молодых специалистов

15 марта 2025
Заседание Совета программы «Приоритет-2030»

14 марта 2025
Заседание Совета программы «Приоритет-2030»

13 марта 2025
Заседание Совета программы «Приоритет-2030»

12 марта 2025
Заседание Совета программы «Приоритет-2030»

11 марта 2025
Заседание Комиссии программы «Приоритет-2030». Дальневосточные университеты

11 марта 2025
КамГУ имени Витуса Беринга и «ЗН Геотерм» создают на Камчатке Центр компетенций геотермальной энергетики

11 марта 2025
Заседание Комиссии программы «Приоритет-2030». Творческие вузы.

10 марта 2025
Заседание Комиссии программы «Приоритет-2030». Кандидаты

9 марта 2025
Вузы-участники программы «Приоритет-2030» представят программы развития

8 марта 2025
Наталья Черкашина: «Ученый — такая же профессия для женщины, как и все остальные»

4 марта 2025
БГМУ Минздрава России реализует цифровую трансформацию в медицине
